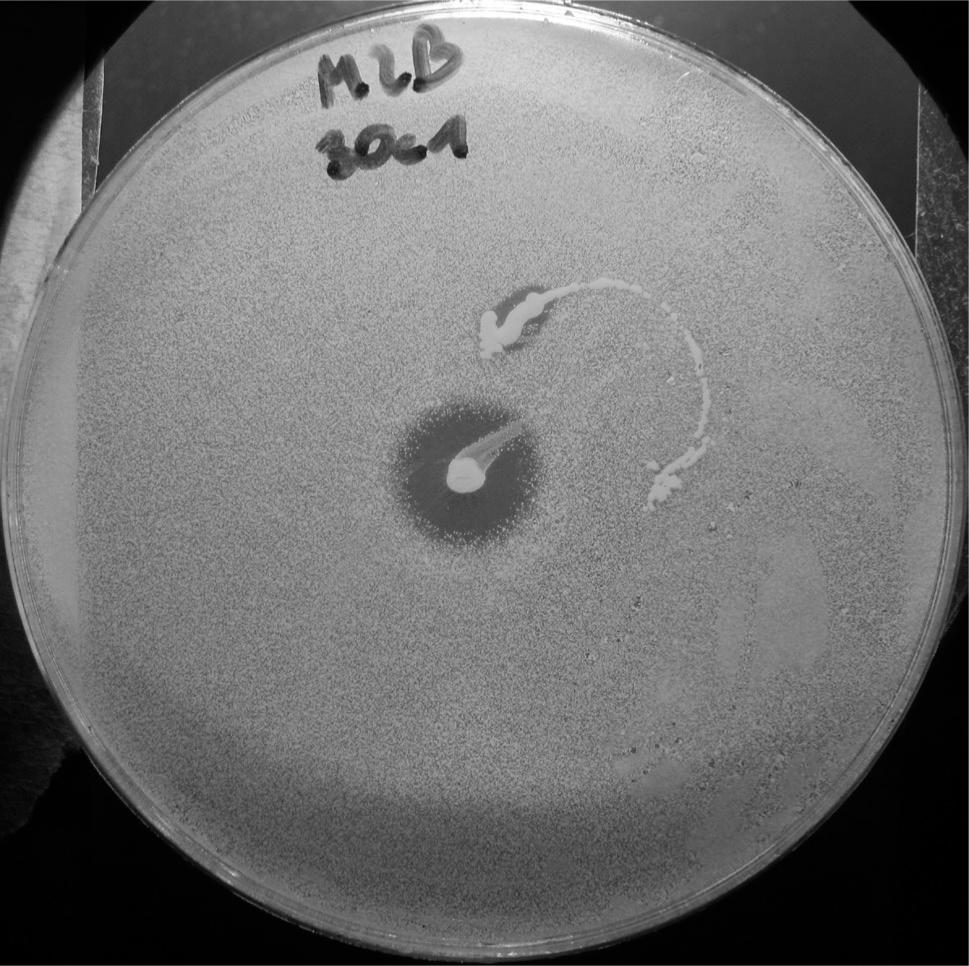
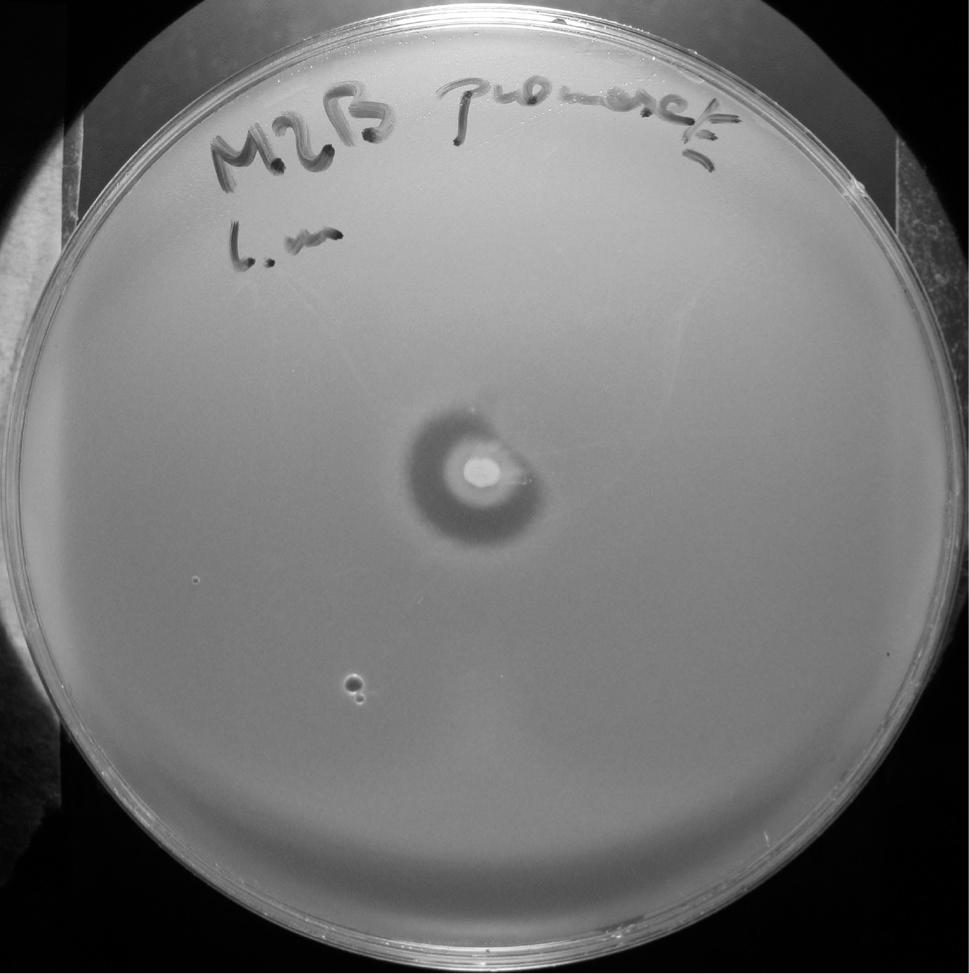
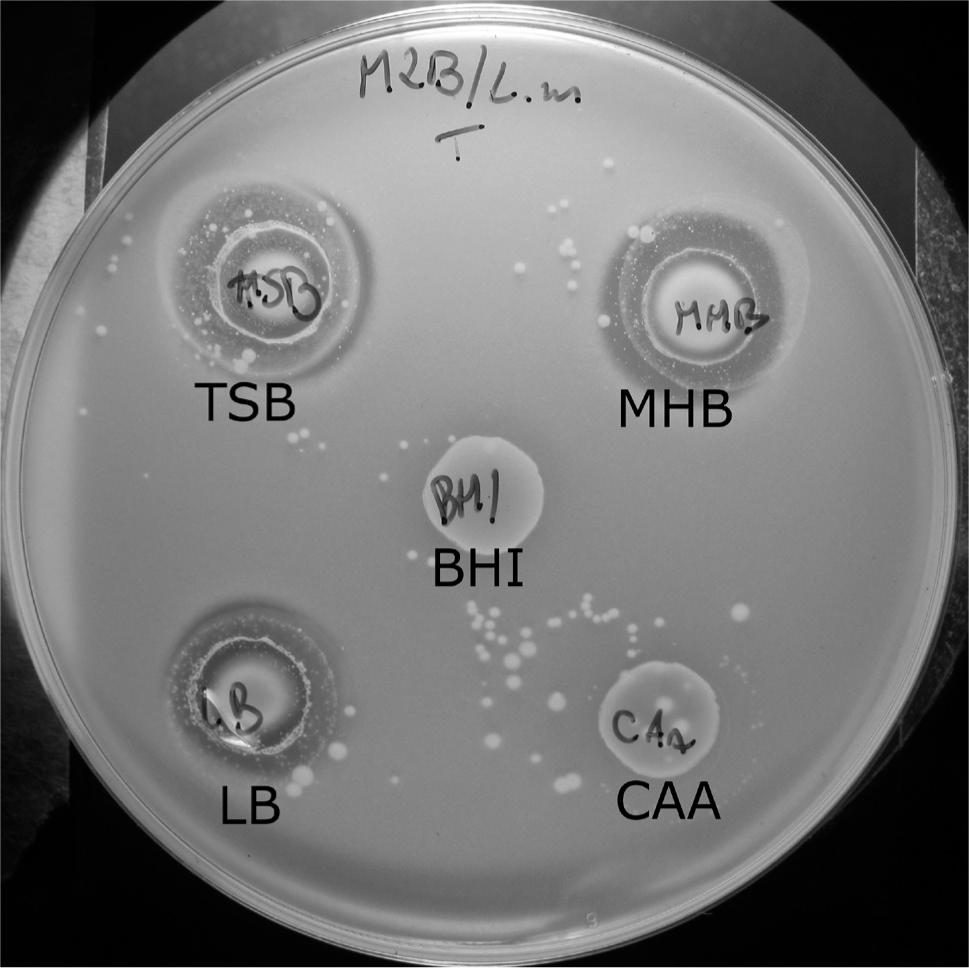

Bacterial cells may produce several types of substances that inhibit the growth of other microorganisms. These antimicrobial agents belong to different classes of molecules, ranging from the simple compounds, like hydrogen peroxide or lactic acid to more complicated: antibiotics, peptides, exotoxins or lytic enzymes (Brito et al., 2011). Among them, the agents of proteinaceous nature, peptides and proteins, seem to be especially interesting. Bacteria produce two essential classes of products of this type: bacteriocins and peptide antibiotics. Both of them are secreted to help the host strain to eliminate other microorganisms from the place of its growth. However, there are some important differences between these two classes of agents. First of all, enzymes synthesize the peptide antibiotics, whilst the bacteriocins are ribosomally synthesized. Bacteriocins are targeted at a narrow spectrum of bacteria often within the species of the producer or closely related ones, while the classical antibiotics are active against broad spectra of bacteria. Another important feature that separates bacteriocins from antibiotics is their potency against susceptible bacteria; bacteriocins are unique because they can kill bacteria at nanomolar concentrations, while antibiotics are needed in much higher concentrations (Nes, 2011). The bacteriocins are included in the larger group of antimicrobial substances defined as antimicrobial peptides (AMPs). These peptides are ribosomally synthesized by all domains of living organisms (eukaryotes, bacteria and archaea). Similarly as bacteria the other organisms (e.g. plants, animals and humans) produce AMPs for elimination of pathogenic microorganisms and prevention of infections (AMPs constitute an important element of their innate immune system) (Rashid et al., 2016). AMPs such as human defensins, human neutrophil peptides and many bacterial bacteriocins are cationic and are able to bind to anionic parts of bacterial surface (e.g. anionic lipids or other anionic components) (Joerger, 2003). AMP’s could undergo posttranslational modification e.g. proteolytic processing or glycosylation (Rashid et al., 2016).
The modes of action of AMPs, including most of the bacteriocins, involve interactions with the bacterial cell membrane, and forming complexes with lipid II – a highly conserved precursor of the bacterial cell wall (Malanovic and Lohner, 2016). Cell membrane permeabilization leads to efflux of important intracellular molecules such as mono- and divalent ions (K+, Na+, Ca2+ and Mg2+) and ATP (Di Meo et al., 2016; Yeaman and Yount, 2003). Binding the peptides with lipid II inhibits peptidoglycan synthesis and additionally promotes pore formation and membrane disruption (Malanovic and Lohner, 2016). Structure-activity analyses of a broad range of peptides showed two main requirements for their antimicrobial activity: (1) a cationic charge and (2) an induced amphipathic conformation. The diversity of lipids among pathogens could explain the differences in activity of a single peptide between different types of microorganisms (Powers and Hancock, 2003).
Due to high selectivity and activity against a substantial array of pathogenic microorganisms, AMP’s are a promising alternative to conventional antibacterial antibiotics (Kosikowska and Lesner, 2016; Ołdak and Zielińska, 2017). Compared to conventional antibiotic therapy, killing of microorganisms by peptides is more rapid and they can ‘attack’ multiple molecular targets related to membrane and cell wall, which highly prevents development of resistant strains. However, the results of recent years revealed that many important Gram-positive as well as Gram-negative bacteria, including dangerous human and animal pathogens, have developed mechanisms of modification of most important molecular targets of AMPs, namely cell membrane and lipid II. As a consequence these strains are highly resistant to AMPs’ activity (Andersson et al., 2016).
In the present study, a collection of Staphylococcus spp. strains isolated from human skin wounds, soft tissues infections, as well as from milk of bovine suffering from mastitis (S. aureus, S. epidermidis, S. xylosus) was screened for their ability to produce antibacterials, particularly with proteinaceous structure, with activity against other staphylococci. This research was focused on identification and preliminary characterization of the newly discovered antimicrobial peptides in order to uncover their potential therapeutic application in medicine and veterinary science for elimination of pathogenic bacteria from food products and also possibilities of their large-scale production.
Bacterial strains.Staphylococcus spp. strains (n = 206) were isolated from milk of bovine suffering from mastitis (n = 158) (Jakubczak et al., 2007; Kot et al., 2012) and from human skin wounds and soft tissue infections (n = 48). Eighteen of the human derived isolates (collected in 2013) were supplied by the Microbial Laboratory at the Provincial Hospital, Koszalin (Poland) and thirty strains were obtained from the Department of Clinical Microbiology, Central Hospital, Vaxjo (Sweden, collected between November 2006 and April 2007) (Sjölund and Kahlmeter, 2008). All isolates of human origin were classified as S. aureus (n = 48) and strains isolated from milk belonged to three species: S. aureus (n = 120), S. epidermidis (n = 16) and S. xylosus (n = 22). The strains isolated from mastitis were collected in two periods of time: between January 2005 and December 2006 (90 isolates of S. aureus) and between February 2009 and March 2010 (all S. epidermidis and S. xylosus and remaining S. aureus). Additionally Listeria monocytogenes and Micrococcus luteus strains were used as indicatory strains in antimicrobial activity assays. All strains were grown in liquid Tryptic Soy Broth – TSB (Fluka) and on solid Tryptic Soy Agar – TSA (Tryptic Soy Broth + 1.5% agar (Sigma)). The strains were stored at –70°C as a cell suspension in PBS buffer (Phosphate Buffered Saline, pH 7.4; Sigma) containing 40% glycerol (vol/vol).
Detection of AMP production. Production of antimicrobial substances by staphylococcal cells was evaluated by the overlay method (Barefoot and Klaenhammer, 1983; Fleming et al., 1975). The single colony (obtained by streaking on TSA agar plates) of the producing strains was transferred with a sterile needle or toothpick on fresh TSA agar plates. After 24 hours of incubation at 37°C, the plates with a single, centrally located, colony – spot of potential producer strains were overlaid with soft TSA medium (Triptic Soy Broth supplemented with 0.75% Agar) inoculated with cells of the sensitive (indicator) strain to a final concentration of 0.01% (vol/vol). Volume of the soft agar depended on the size of the plate, where soft agar should completely cover the surface of the bottom TSA medium and the producer strain colony. The indicator strains (n = 7) included six staphylococci strains isolated from animal infections (1 – S. xylosus, 1 – S. epidermidis and 4 – S. aureus) and one strain of Listeria monocytogenes ATCC10425 (Table I). After inoculation, the plates were incubated at 37°C for another 24 h, and the growth inhibition of the indicator cells was determined. The presence of a clear zone around the producer strain colony confirmed production of an active antimicrobial agent. The diameter of the growth inhibitory zone was measured.
The indicator strains used for preliminary selections of staphylococci producing antibacterial agents.
| Strain | Source of the strain | Resistance |
|---|---|---|
| 1 S. xylosus 30c1 | Bovine mastitis | ND |
| 2 S. epidermidis 267 | Bovine mastitis | ND |
| 3 S. aureus K10 | Human skin wound (Koszalin) | Susceptible |
| 4 S. aureus 11 | Bovine mastitis | P, AMP, AML, S, AMC* |
| 5 S. aureus 27 | Bovine mastitis | N, MY, S, E, DA* |
| 6 S. aureus 101 (MRSA) | Bovine mastitis | P+DA+E+MY+S+N/OX* |
| 7 L. monocytogenes ATCC10425 | Reference strain | ND |
– Resistance according to Szweda et al. 2014
Antibacterial activity of the after-culture liquid medium was measured by the agar-well diffusion method (Schillinger and Lücke, 1989). The strains found as producers of antimicrobial agents on TSA agar plates (n = 6) were grown in TSB for 24 hours at 37°C. The obtained cell suspensions were centrifuged (14 000 rpm, 10 min, room temperature) to collect the bacterial cells. The collected and filter sterilized (0.22 μm) supernatants (300 μl) were aliquoted into wells (diameter 7 mm) in solid TSA medium (TSB medium supplemented with 1.5% agar). The plates were dried in a laminar flow cabinet, and when the supernatant evaporated completely from the wells, the plates were overlaid with a soft agar layer inoculated with the cells of indicator strains to a final concentration of 0.01% (vol/vol). After incubation (24 h, 37°C), the diameters of clear zones were measured.
Identification of the antimicrobials with proteinaceus nature. The overlay method (described above, section – Detection of AMP production) was also used for identification of proteinaceus nature of antimicrobials produced by the selected strains. The 2 μl of solution of proteolytic enzymes (Pronase E (20 mg/ml), α-Chymotrypsin (25 mg/ml) and Proteinase K (20 mg/ml) (Lee et al., 2008)) were loaded on the surface of the bottom agar medium close to the growing colony of the producing strain – on the suspected border line of inhibition growth zone of indicator strain. The prediction of the diameter of the growth inhibition zone was based on diameters of inhibition area from the results of previous analyses. The changing of the shape of growth inhibition zone – formation of so-called “half moon zone” near the colony of producing strain confirmed susceptibility of the produced agent to the proteolytic enzymes and that the secreted product had the proteinaceus nature.
Determination of the activity spectrum of the identified AMPs. Determination of the potential antimicrobial peptide activity spectrum was performed by the overlay method (as used in the previous tests, section – Detection of AMP production) for the producer strains, which showed protease sensitivity (n = 3). All of the isolates from the collection of Department of Pharmaceutical Technology and Biochemistry, Gdansk University of Technology (n = 206) were used to define their susceptibility to the potential antimicrobial peptide. The most sensitive strain (n = 1) was selected for investigation of the antimicrobial activity in further tests, e.g. the optimization of production or determination of thermostability.
Optimization of AMP production parameters. The conditions for the most effective production of the bacteriocins by the strains selected in the screening procedure were optimized in terms of: (1) medium type (Tryptic Soy Broth (TSB; DB Bioscience), Mueller Hinton Broth (MHB; DB Bioscience), Brain Heart Infusion (BHI; DB Bioscience), Casamino acids (CAA; DB Bioscience) and Luria-Bertani (LB; BD Bioscience); (2) temperature (30°C, 35°C, 37°C), and (3) the growth period (12 h, 24 h and 48 h, 72 h). The cells were grown in suspension cultures with shaking (200 rpm). Samples of the cell suspensions were collected at time intervals (0 h, 3 h, 6 h, 9 h, 12 h, 24 h, 48 h, 72 h), centrifuged (10 000 rpm, 10 min, 4°C) and the activity of the supernatants obtained was determined by the well – overlay method. The first step of the procedure was performed for all (n = 3) producer strains, which exhibited sensitivity to proteolytic enzymes (S. xylosus M2B, S. epidermidis 30c1 and S. aureus K1). After that step, we found out that only one antimicrobial peptide, produced by strain named M2B (S. xylosus), was efficiently secreted to liquid medium. Thus, other tests were performed only for this strain.
Determination of thermostability. Sample of the supernatant collected from the cultures after 24 h of antimicrobial-producing strain were incubated at 25°C, 50°C, 65°C, 70°C, 75°C, 80°C, 85°C, 90°C for different time periods (5 min, 10 min, 15 min, 30 min) and their activity was determined by the well-overlay method.
Identification of the strain. Identification of the producing strain M2B was carried out by sequencing of 16S rRNA gene. PCR amplification of the target gene was carried out with a pair of primers:
rP1 5’ CCCGGGATCCAAGCTTAGAGTTTGATCCTGGCTCAG 3’
fD2 5’ CCGAATTCGTCGACAACACGGCTACCTTGTTACGACTT 3’
Screening of the 206 bacterial isolates resulted in the identification of six strains producing antistaphylococcal agents. Three producing strains were S. aureus isolated from bovine mastitis (assigned in the collection as 30, 31 and 32), one was S. aureus recovered from human skin wound (K1), one agent was produced by S. xylosus M2B and the last of producing strain was S. epidermidis 30c1. The antibacterial activity of three (produced by S. aureus 30, 31 and 32) out of six substances was not affected by the treatment with proteolytic enzymes, suggesting their non-proteinaceous structure. Further tests eliminated two additional strains (K1 and 30c1), since they produced antimicrobial substances exclusively when grown on solid (agar) medium while no antibacterial activity was detected in the supernatants collected from the suspension cultures. Therefore, completion of the screening procedure resulted in the identification of one strain effectively producing the antibacterial substance with protease-sensitive structure, i.e. potential bacteriocin or peptide antibiotic. This strain (M2B) and the produced agent were the subjects of further analysis.
Based on the sequence of the gene coding for 16S rRNA, the producing strain was identified as S. xylosus (99,9% of identity of this gene sequence with the sequences of 16S rRNA genes of other bacteria of the this genus) – labeled in the collection as M2B. The antimicrobial agent synthesized by this strain was efficiently produced both on solid as well as in a liquid medium (Fig. 1a and Fig. 2) and its’ activity was eliminated in the presence of proteases (Fig. 3).
Growth inhibition zone around the colony of producer strain M2B; an indicator strain – S. aureus 30C1.
Formation of “half moon zone” near the colony of producer strain M2B in the presence of proteolytic enzyme; an indicator strain – L. monocytogenes.
Antimicrobial activity of the after-culture liquid media after growth of the producer strain.
The antimicrobial spectrum of the putative antimicrobial peptide produced by S. xylosus M2B was determined by the well overlay method. Growth inhibition zones were observed with 13 strains of staphylococci (including nine S. aureus, three S. xylosus and one S. epidermidis strains), L. monocytogenes and M. luteus (Table II). Diameters of the growth inhibitory zones were in the range of 12–25 mm; surprisingly apparent substantial differences in sensitivity to the putative AMPs were found among the different S. aureus strains.
Activity of newly identified agent against strains from the Departments’ collection.
| No. of strain | Code number of the sensitive strain | Growth inhibition zone [mm] |
|---|---|---|
| 1 | 7 (S. aureus) | 12 |
| 2 | 11 (S. aureus) | 20 |
| 3 | 28 (S. aureus) | 15 |
| 4 | 52 (S. aureus) | 22 |
| 5 | 68 (S. aureus) | 25 |
| 6 | 77 (S. aureus) | 18 |
| 7 | 92 (S. aureus) | 17 |
| 8 | 99 (S. aureus) | 25 |
| 9 | 115 (S. aureus) | 15 |
| 10 | 83A (S. epidermidis) | 15 |
| 11 | 8J (S. xylosus) | 15 |
| 12 | 30C1 (S. xylosus) | 15 |
| 13 | 247 (S. xylosus) | 15 |
| 14 | L. monocytogenes | 15 |
| 15 | M. luteus | 15 |
Conditions for the effective production of the putative bacteriocin by S. xylosus M2B in a liquid culture were optimized in the terms of medium type, time period and incubation temperature. Comparison of the production efficiency in five different commercially available media, recommended for staphylococci culture, revealed that the optimal production of the putative AMP was observed in TSB medium. Slightly lower level of peptide production was found in MHB and LB media and no production was detected in CAA and BHI media (Fig. 2).
The maximum level of AMP production by S. xylosus M2B was observed after 24 h of incubation in TSB medium, and the optimal temperature was 37°C.
The tests of thermostability revealed that the putative antimicrobial peptide did not lose its activity after 15 minutes of heating at 90°C. After 30 min of incubation in 90°C peptide lost its activity (inhibition zone was significantly smaller).
Studies on the antimicrobial substances produced by staphylococci, have not been very extensive so far. However, there are a few peptides exhibiting antistaphylococcal activity produced by bacteria that belong to this genus, including both CNS – coagulase negative and CPS – coagulase positive staphylococci. The most promising examples of AMPs produced by CNS are the following bacteriocins: Pep5, epicidin 280, epilancin K7, epidermin, nukacin ISK-1, simulancin 3299, and the most extensively characterized bacteriocins produced by CPS are: staphylococcin C55, aureocin A70, aureocin A53 (Nascimento et al., 2006; Varella Coelho et al., 2007). The detailed characteristics of the best characterized staphylococcins has been presented in the review by Bastos and coworkers (Bastos et al., 2009). The authors also emphasized that staphylococcins may be applied, solely or in a combination with other chemical agents. The use of combinations of antimicrobials is common in the clinical setting, and the most important advantages coming from such approach are: 1) expanding the spectrum of organisms that can be targeted, 2) prevention of the emergence of resistant organisms, 3) decreasing of toxicity by allowing lower doses of both agents (Kurlenda and Grinholc, 2012).
Our studies, results of which are presented in this work, are probably one of the very few examples of an extensive screening aimed at the identification of antimicrobial peptides produced by staphylococci isolated from humans (skin and soft tissue infections n = 48) or animals (strains isolated from bovine with mastitis n = 158). From the set of 206 strains, we identified six strains producing any antimicrobials (2.9%), of which, one was confirmed to be a putative peptide or protein with antimicrobial activity, efficiently produced in a liquid medium. Two out of three antimicrobial – producing strains identified in these studies did not produce the antimicrobial agents at the detectable level when grown in liquid media. Similar problems were recently observed by Braem and coworkers (2014), who identified Staphylococcus chromogenes L217 strain (isolated from teat apices of dairy cows) producing nukacin-like bacteriocin displaying a broad spectrum of antimicrobial activity. Unfortunately, the bacteriocin was only produced in significant quantities when the producer strain was grown on solid agar medium.
The molecular structure of the putative AMP produced by S. xylosus M2B is not known until now. This work is in progress in our laboratory, but preliminary results indicate that it could be a novel, previously undescribed compound. Its antimicrobial spectrum is interesting, since it is relatively narrow. Additionally, the good thermostability is advantageous, which could be especially important in the case of potential application of the identified antimicrobial peptide for the elimination of staphylococci from food products, but also for purification procedure, e.g. preliminary separation of the peptide from other components of the cell free after-culture supernatant by the heat treatment.
The produced peptide exhibits also strong activity against other important foodborne pathogenic bacteria L. monocytogenes. Thus, it could be also applied for protection of food products against these bacteria.
The recent studies carried out by Hewelt-Belka and coworkers (2016) revealed some important differences in the lipid composition of S. aureus clinical isolates. The observed, by the mentioned authors, differences in the lipid patterns between sensitive and resistant S. aureus strains suggest that antibiotic susceptibility may be associated with the lipid composition of bacterial cells. The lipids that were found to significantly differ between antibiotic-resistant and antibiotic-sensitive clinical isolates are involved in the biosynthesis of major S. aureus membrane lipids and lipoteichoic acid. The research of Powers and Hancock (2003) revealed that the lipid composition of the bacterial cell membrane is crucial for AMPs activity. Thus the observed in our studies differences in the susceptibility of Staphylococcus spp. strains tested to the agent produced by M2B can be caused by some differences in the lipid composition of their cell membranes.
In our studies, the prevalence of isolation of strains producing AMPs was found to be at a relatively low level – below 2% (three out of 206 isolates), and only one strain (prevalence below 0.5%) produced a peptide that is worthy of further studies. However, we do not have any doubts that staphylococci represents an interesting and promising source of uncharacterized antimicrobial peptides, which could be used for treatment or prophylaxis of infections caused by other bacteria that belong to the Staphylococcus spp. but also other important pathogenic microorganisms e.g. L. monocytogenes. Unfortunately, the research in this field is limited. Each year, numerous publications concerning the antibiotic resistance of the staphylococci isolated from both, human and animal (especially bovine mastitis) infections from different world regions are presented. In the case of some of these publications, large populations, counting even several hundreds of isolates, are investigated. Unfortunately, very few of these isolates are investigated for their potential production of antimicrobial agents. The methods used for screening the ‘producing strains’ are relatively easy and could be performed in most of microbiological laboratories. Thus, we encourage other research groups, which have access to the large number of human or animal isolates of staphylococci, for investigation of the production ability of potential antimicrobial peptides by these strains.